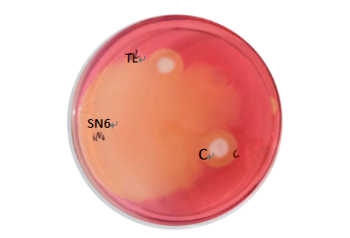

在行业整体承压、挑战重重的上半年,华大瑞尔不仅没有放缓脚步,反而在逆风中跑出了加速度!7月9-11日,公司隆重召开年中销售会议,多项数据飘红,营收同比增长22.8%,超额完成既定目标。客户的成本压力和饲养技术的痛点就是我们创新发展的动力,困难时期,华大瑞尔以产品力诠释了“韧性生长”的深刻内涵。
核心产品线表现强劲——优力爱、魏净、唯特菌康、植华饲、百羽千鑫、美益等拳头产品继续驰骋市场,新锐产品反促1号Plus凭借独特的菌株优势、精准的市场定位以及40多例成功的终端实战验证,获得广大客户认可,快速打开局面,成为新的增长引擎。
附:反促1号Plus实证资料
反促1号Plus核心菌株为华大瑞尔自主开发的高产纤维素酶和木质素酶的益生菌SN-6,经过科学复配,能有效提升粗饲料利用率,显著提高动物采食、促进增重、调理反刍、减少躁动。
SN-6产纤维素酶能力验证
SN-6产木质素酶能力验证
↓
使用前后粪便对比
采食后安静反刍
长期使用群体骨架开张,
背膘均匀,皮光毛顺
市场拓展成效显著
上半年,我们赢得了更多客户的信任,累计开发价值新客户65个。
辽宁、内蒙、贵州、重庆等新兴市场增长强劲。
这既是客户的信任,更是检验产品和服务的试金石。
客户的选择,我们须加倍珍惜!我们将以更高的标准服务客户,确保每一位客户都能感受到我们的诚意与实力。
打造胜利之师,不止于产品品质的提升和专业服务的精进。会议期间,团队活动亦有别样的精彩——

职工篮球赛精彩瞬间

友谊第一 比赛第二
为胜利喝彩

参赛队员赛后合影

台王争霸赛前组队

经过激烈角逐,冠亚季军各有归属

台王三剑客:冠军李雄,亚军周健,季军周轩

台王争霸赛冠军风采
如何将上半年的“亮眼”转化为下半年的“耀眼”,公司全体同仁将凝心聚力,锐意进取,向年度目标发起全力冲刺,共同谱写高质量发展的新篇章!



